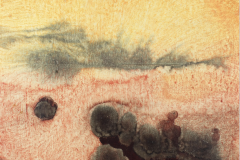
Ithell Colquhoun

Collection of mediumistic and visionary art
Dating from the 1850s to the present day, this collection of mediumistic and visionary art celebrates artists who have demonstrated unique forms of visual expression, with many pushing beyond the material world to perceive new realities in the immaterial. Some created their work under the guidance of the spirit world, while others drew upon intuition, trance states, or clairvoyant visions. Free from the constraints of academic convention, these mediums and visionaries often embraced automatic techniques as an alternative forms of mark making. Their subject matter was equally unconventional: strange esoteric symbols, unknown alphabets, primordial beings, fairies and elementals, extraterrestrial landscapes, abstract energies, sound and thought forms and gloriously numinous flora are all part of their rich visual language.
The aim of this growing collection is to preserve and shine a light on this wellspring of enigmatic creativity, giving voice to artists who have been overlooked in art history. Whether through research, talks and publications, curating shows or loans to exhibitions, we invite audiences through observation, collaboration, conversation and contribution to help expand the understanding and appreciation of this extraordinary genre of artistic expression.
Learn more about the artists in the collection by clicking on the thumbnails below.